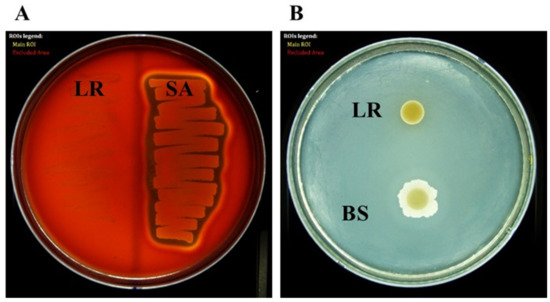

Abstract
We isolated and characterized Limosilactobacillus reuteri PSC102 and evaluated its probiotic, antioxidant, and antibacterial properties. We preliminarily isolated 154 candidates from pig feces and analyzed their Gram nature, morphology, and lactic acid production ability. Based on the results, we selected eight isolates and tested their ability to produce digestive enzymes. Finally, we identified one isolate using 16S rRNA gene sequencing, namely, L. reuteri PSC102. We tested its probiotic properties in vitro, including extracellular enzyme activities, low pH and bile salt tolerance, autoaggregation and coaggregation abilities, adhesion to Caco-2 cells, antibiotic susceptibility, and hemolytic and gelatinase activities. Antioxidant activity was determined using 1-diphenyl-2-picrylhydrazyl and 2-azinobis-(3-ethylbenzothiazoline-6-sulfonic acid) diammonium salt radical scavenging and reducing power assays. The antibacterial activity of this strain and its culture supernatant against enterotoxigenic Escherichia coli were evaluated using a time-kill assay and disk diffusion method, respectively. L. reuteri PSC102 exhibited tolerance toward low pH and bile salt and did not produce harmful enzymes or possess hemolytic and gelatinase activities. Its intact cells and cell-free extract exhibited potential antioxidant activities, and significantly inhibited the growth of enterotoxigenic E. coli. Our results demonstrate that L. reuteri PSC102 is a potential probiotic candidate for developing functional feed.
1. Introduction
Recently, the use of probiotics as growth promoters and alternatives to antibiotics for farm animals, including pigs, has increased significantly [1]. In farm animals, probiotics improve feed utilization efficiency, modulate immunity, and prevent gastrointestinal (GI) infections by developing GI health [2]. Among other probiotics, lactic acid bacteria (LAB) are potential sources of feed supplements for swine nutrition, and are effective for producing functional feeds [3,4,5]. Hence, it is important to evaluate the probiotic features of LAB strains isolated from various sources before utilizing them in functional feed products [6]. Live probiotics must be safe for consumption, capable of surviving in the GI tract, have beneficial characteristics, and be used effectively [7]. Furthermore, they should be able to adhere and multiply in the gut, tolerate bile salt concentrations and gastric acidity, and possess autoaggregation and coaggregation abilities. Moreover, they should not produce any harmful enzymes or exhibit hemolytic and gelatinase activities [8].
LAB possessing antioxidant properties, including free radical scavenging, reducing power, and enzyme inhibition, might ameliorate stress-related disorders. This increases the growth performance of the host by counteracting the reactive oxygen metabolites created during normal cellular processes, such as protein damage, modification of beneficial lipoproteins, mutation of DNA, and oxidation of phospholipids [9,10,11].
Infectious diseases, such as GI infections, are serious threats to swine production as they cause severe illness and death in swine populations [12]. Noninfectious bacteria, such as probiotics, can help maintain mucosal integrity and thus prevent infections by reducing paracellular permeability, defending against pathogens, and increasing the physical barrier of the mucosal layer [13,14]. Probiotic LAB and their culture supernatants can be used as antibacterial components for treating bacterial infections [15]. Previous studies have demonstrated that the production of different antibacterial components by Lactobacillus, such as organic acids (acetic and lactic acids), proteinaceous compounds (bacteriocins), and miscellaneous compounds (reuterin), can act as selective barriers against GI pathogens [16,17].
Factors such as the safety profile of probiotics, their survivability in standard GI tract conditions, and other potential benefits must be considered while screening probiotic bacteria [18]. Therefore, this study aimed to isolate, characterize, and identify a new probiotic strain, L. reuteri PSC102, and evaluate its potential probiotic, antioxidant, and antibacterial properties.
2. Materials and Methods
2.1. Bacterial Strains, Culture Conditions, and Media
Different bacterial strains were used in this study. Escherichia coli strains (KVCC1423, KVCC0543, and KVCC0306) were provided by the National Veterinary Research and Quarantine Service (Gimcheon, South Korea) [19]. E. coli ATCC 35,218, Bacillus subtilis KCTC 1021, Staphylococcus aureus ATCC 29,213, Lactobacillus acidophilus KCTC 3146, and Limosilactobacillus reuteri KCTC 3594 were used as quality control strains. All E. coli strains were grown in Luria-Bertani (LB) Broth (Difco, Sparks, MD, USA). L. reuteri and L. acidophilus were cultured in De Man, Rogosa, and Sharpe (MRS) broth (MB Cell, SeoCho-Gu, Seoul, Korea).
2.2. Isolation and Selection of L. reuteri PSC102
We collected fecal samples from 80 commercial weaning piglets (Duroc × Landrace × Yorkshire) from breeding farms in Kyungsan city, Gyeonsangbuk province, South Korea. Healthy weaning piglets (weighing 8.5 ± 0.7 kg, aged 4–5 weeks) were not administered any antibiotics or probiotics, and were fed a normal diet. Fecal samples were collected by rectal palpation using sterile swabs. Samples were collected in individual sterile flasks, stored under refrigeration, transported to the laboratory, and processed within 3 h of collection. Lactobacilli strains were isolated from the fecal samples as previously described [20,21]. The experiment was exempted from review by the institutional animal care and use committee because it did not involve direct experimentation on the animals.
Briefly, 1 g fecal sample was mixed and homogenized with 9 mL of diluent that consisted of 4.5 g dipotassium hydrogen phosphate (Sigma-Aldrich, St. Louis, MO, USA), 0.5 g L-cystein (Duksan, Daejon, Korea), 0.5 g Tween 80 (Difco, Sparks, MD, USA), and 1 g Bacto agar (Becton, Dickinson and Company, Sparks, MD, USA) in 1 L of distilled water. Then, 1 mL of this solution was serially diluted 10-fold using 0.1% Bacto agar saline. Each diluted solution was streaked on an MRS agar (MB Cell, SeoCho-Gu, Seoul, Korea) plate, followed by anaerobic incubation for 48 h at 37 °C. Each colony was examined for appearance, Gram staining, microscopic cell morphology, catalase generation by H2O2 (KPL, Gaithersburg, MD, USA), acid production on MRS agar using 0.2% calcium carbonate (Sigma-Aldrich, St. Louis, MO, USA), and lactic acid production using a lactic acid detection kit (Accuvin LLC, Napa, CA, USA). LAB were selected based on their ability to produce dietary enzymes, including protease, lipase, amylase, and phytase, in a modified MRS agar medium (pH 7). Subsequently, they were grown on an MRS agar plate containing 0.2% methyl cellulose and 0.2% corn starch. After 48 h of anaerobic incubation, 0.2% Congo agar red reagent was added to the modified MRS agar. After 30 min, 1 M NaCl was added to decolorize the medium, and the colonies were identified by observing a surrounding halo zone.
To isolate LAB producing a specific enzyme, such as protease, lipase, amylase, and phytase, the colonies were assayed for halo formation on specific media as previously described [20]. Protease-producing colonies were screened by incubating them for 48 h on 1.5% agar medium containing 1% beef extract, 0.5% polypeptide, 0.5% milk casein, and 0.5% NaCl. Lipase-producing colonies were screened by incubating them for 48 h on 1.5% agar medium containing 0.1% tryptone, 0.5% yeast extract, 0.05% NaCl, and 0.1% tricaprylin. Phytase-producing colonies were screened by incubating them for 48 h on 1.5% agar medium containing 1.5% D-glucose, 0.5% calcium phytate, 0.5% NH4NO3, 0.05% MgSO4.7H2O, 0.01% MnSO4.7H2O, 0.05% KCl, 0.001% FeSO4.7H2O, and 0.01% MnSO4.4H2O. Amylase-producing colonies were screened by incubating them for 48 h on 1.5% agar medium containing 0.5% polypeptone, 0.5% beef extract, 0.2% yeast extract, 0.2% NaCl, and 2% starch. After 48 h of incubation under anaerobic conditions, the media were examined for colonies with a halo zone. The LAB that could produce all the tested enzymes were subcultured and stored at −70 °C for subsequent analysis.
2.3. Identification of L. reuteri PSC102
We identified the strain by analyzing the 16S rRNA gene sequence. Briefly, we extracted the genomic DNA from the isolated strain using a genomic DNA extraction kit (Qiagen Inc., Hilden, Germany) and performed polymerase chain reaction (PCR) using forward and reverse primers (5′-AGGTAACGGCTTACCAAGGC-3′ and 5′-CCACCGCTACACATGGAGTT-3′, respectively). A PCR mixture containing 50 pmole primers, 50 ng template DNA, 5 μL of 10× Taq DNA polymerase buffer, and 1 U of Taq DNA polymerase (Takara, Japan) was denatured at 94 °C for 5 min and then at 95 °C for 30 s. The PCR included 35 cycles with annealing for 30 s at 56 °C, elongation at 72 °C for 30 s, and then final extension for 7 min at 72 °C. BLAST software (version 2.8.1) was used to compare closely related sequences retrieved from the GenBank database.
2.4. Scanning Electron Microscopy (SEM) Analysis
SEM was used to observe the morphology of L. reuteri PSC102 as previously described [22]. Briefly, L. reuteri PSC102 cells were fixed in 2.5% glutaraldehyde in phosphate-buffered saline (PBS) for 2 h and then washed thrice with PBS. After washing, the bacterial cells were dehydrated using graded ethanol concentrations of 30, 50, 70, 80, 90, and 100%. The samples were frozen overnight at −70 °C followed by lyophilization in a vacuum freeze dryer (Operon Advantech Co., Ltd., Gyeonggi, South Korea) for 24 h. The prepared samples were sputter-coated with gold-palladium and analyzed using SEM (S-4300; Hitachi, Tokyo, Japan).
2.5. Characterization of L. reuteri PSC102
To establish a culture system, we tested the glycolytic capacity of L. reuteri PSC102 using the API 50 CHL kit according to the manufacturer’s instructions (API Biomerieux, Durham, NC, USA). L. reuteri PSC102 was suspended in API 50 CHL media, dispensed into strips, and incubated for 48 h at 37 °C. The reading of the strip was determined as negative (−) or positive (+) based on the color change of each tube.
2.6. Extracellular Enzyme Activities
We used the API-ZYM kit (Biomeriux, Marcy-I’Etoile, France) to measure the extracellular enzymatic activities according to the manufacturer’s instructions. Briefly, a single colony of L. reuteri PSC102 was inoculated in MRS broth and incubated at 37 °C overnight. After centrifugation, the collected cell pellets were mixed with the provided API suspension (0.85% saline), and the turbidity was adjusted with the supplied McFarland 0.5 standard. Next, 65 µL of cell suspension was loaded into each of the 20 cupules of the supplied strip, and then the strip was inserted into the supplied moisture box to prevent drying. After incubation for 4 h at 37 °C, the ZYM-A and ZYM-B reagents were then added dropwise into each cupule. The color changes were observed after 5 min and compared with the manufacturer’s standard response chart. The results were graded from 0 (no activity) to 5 (maximum activity) based on the color intensity per the manufacturer’s instructions.
2.7. Acid Tolerance Test
The survivability of L. reuteri PSC102 in a low pH milieu was accomplished by measuring the survivable colony counts. Briefly, 1 N HCl was added to 5 mL of MRS medium to adjust the pH to 2, 3, 4, 5, and 7 (control), and then 105 CFU/mL L. reuteri PSC102 and L. reuteri KCCM 40,717 were added, and growth was confirmed at 0, 1, 6, and 12 h intervals by incubation at 37 °C. The number of viable colonies, expressed as log CFU/mL, was determined by evaluating the sample at designated time points and incubating on MRS agar plates.
2.8. Bile Tolerance Test
The resistance of L. reuteri PSC102 to bile salts was measured by evaluating its survivability in sterile MRS broth (5 mL) supplemented with different bile salt concentrations (0, 0.1, 0.3, and 1% DifcoTM Oxgall, BD, Franklin Lakes, NJ, SUA) as previously described [23]. Subsequently, L. reuteri PSC102 and KCCM 40,717 cells were diluted to 105 CFU/mL and incubated at 37 °C. The number of viable colonies (expressed as log CFU/mL) was determined by taking the samples at 0, 1, 6, and 12 h, followed by incubation on MRS agar plates.
2.9. Autoaggregation and Coaggregation Assay
We evaluated the autoaggregation ability of L. reuteri PSC102 as previously described, with slight modification [24]. Overnight bacterial culture was harvested by centrifugation (5000× g, 4 °C, 10 min) and washed twice with sterile PBS. The pellets were suspended in PBS and the absorbance was maintained at 0.5 ± 0.05 (ODinitial) at 600 nm. The bacterial cell suspension (4 mL) was incubated at 37 °C for different time periods. The percentage of autoaggregation was determined using the following equation:
where ODtime represents the absorbance at 2, 4, 6, 12, or 24 h and ODinitial represents the absorbance at 0 h.
For the coaggregation assay, the bacterial cell suspension (L. reuteri PSC102/pathogenic bacteria) was prepared similarly as the autoaggregation assay. OD600 of the bacterial suspension was maintained at 0.5 ± 0.05. Equal volumes of L. reuteri PSC102 and different pathogenic bacterial cell suspension (2 mL each) were mixed by vortexing for 30 s and incubated for different time periods (2 or 24 h) at 37 °C. The percentage of coaggregation was determined using the following equation:
where ODtime represents the absorbance at 2 or 24 h and ODinitial represents that at 0 h.
2.10. Adhesion to Human Colon Carcinoma (Caco-2) Cells
The adhesion capacity of L. reuteri PSC102 was evaluated using the Caco-2 cell line as previously described [25]. Caco-2 cells were obtained from the Korean Cell Line Bank (Seoul, Korea) and cultured in Roswell Park Memorial Institute (RPMI) medium supplemented with 10% fetal bovine serum albumin and 1% penicillin–streptomycin. The cells were then seeded in a 24-well plate at 105 cells/well and incubated at 37 °C under 5% CO2 until they had formed a confluent monolayer. The medium was replaced every alternate day. After the Caco-2 cell monolayer was formed, the media was replaced with antibiotic-free RPMI media. Next, the cell monolayer was washed thrice with PBS before the adhesion assay. L. reuteri PSC102 (108 CFU/mL) was added to each well to a final volume of 1 mL, followed by incubation for at 37 °C for 3 h. The wells were washed thrice with sterile PBS to eliminate the non-adhered bacteria. Subsequently, 1 mL of 1% (v/v) Triton X-100 was added into each well and the mixture was agitated for 10 min to detach the L. reuteri PSC102 cells from the wells. The cells were serially diluted 10-fold, streaked on an MRS agar plate, and incubated at 37 °C for 24 h to determine the viable cell count. The percentage adhesion rate of L. reuteri PSC102 to Caco-2 cells was determined by dividing the number of adhered bacterial cells (N3 h) with the initial number of bacterial cells (No h) as follows:
2.11. Antibiotic Sensitivity Test
The antibiotic sensitivity of L. reuteri PSC102 was determined against 14 antibiotics, including cephalexin, colistin sulfate, enrofloxacin, cefalonium, amoxicillin trihydrate, penicillin G procaine, norfloxacin, spectinomycin, tylosin base, cefuroxime sodium, florfenicol, penicillin G benzathine, gentamicin sulfate, and streptomycin sulfate (Sigma-Aldrich, St. Louis, MO, USA), as previously described [26]. Briefly, 100 µL of cultured L. reuteri PSC102 was mixed with 100 µL of diluted antibiotic solution in a 96-well plate. After finally adjusting the concentration to 106 CFU/mL, the bacteria were incubated for 24 h at 37 °C. The minimum inhibitory concentration (MIC) and minimum bactericidal concentration (MBC) were determined by measuring the OD value at 600 nm using Gen5 microplate reader version 3.08 (BioTek, Winooski, VT, USA) and by streaking on Mueller–Hinton agar plate, respectively.
2.12. Hemolytic and Gelatinase Activities
The hemolytic activity of L. reuteri PSC102 was assayed using a blood agar plate (BBL Microbiology Systems, Franklin Lakes, NJ, USA). A single colony of L. reuteri PSC102 and S. aureus ATCC 29,213 (positive control) were cultured overnight. The cultured bacterial cells were streaked on blood agar plate and incubated for 24 h at 37 °C. Finally, the nonhemolytic activity was evaluated based on the no inhibition zone around the colony [8]. Gelatinase activity was assayed following a previously reported method [27]. Briefly, 10 µL of fresh L. reuteri PSC102 and B. subtilis KCTC 1021 (positive control) cultures were spotted on nutrient agar (23 g/L) supplemented with gelatin (8 g/L), followed by incubation for 24 h at 37 °C. After incubation, the plates were examined to check for the formation of any opaque halos around the colonies, which indicates gelatinase production.
2.13. Antioxidant Activity
2.13.1. Sample Preparation
The antioxidant effects of the cultured L. reuteri PSC102 intact cells and their cell-free extracts were measured using a previously described method [8]. Briefly, overnight cultured L. reuteri PSC102 was centrifuged (5000× g, 10 min, 4 °C) to obtain the intact cells. The collected pellets were washed twice and resuspended in PBS (pH 7.4), and the OD600 value was adjusted to 0.4 ± 0.05. The cell-free extracts were prepared by ultrasonic (37 kHz for 30 min) disruption of cultured intact cells. The cells were separated by centrifugation for 10 min at 5000× g and 4 °C. The collected supernatants were regarded as cell-free extracts.
2.13.2. 1-Diphenyl-2-Picrylhydrazyl (DPPH) Radical Scavenging Activity
DPPH radical scavenging activity of the intact cells and cell-free extract of L. reuteri PSC102 was measured according to a previously simplified method [8]. Briefly, 2 mL of the prepared sample and 2 mL of 0.4 mM DPPH solution were dissolved in methanol and incubated in the dark for 30 min at 37 °C. The reaction mixtures were incubated and centrifuged for 10 min at 5000× g, and the absorbance of the supernatant was measured at 517 nm. The control consisted of PBS with DPPH but without the sample. The following formula was used to measure the DPPH radical scavenging activity:
2.13.3. 2-Azinobis-(3-Ethylbenzothiazoline-6-Sulfonic acid) Diammonium Salt (ABTS) Radical Scavenging Activity
The ABTS free radical scavenging activity of intact cells and their cell-free extracts was determined based on a previously reported method [8]. The ABTS reagent solution was prepared by mixing 7 mM ABTS stock solution with 7 mM potassium persulfate and kept in the dark overnight at room temperature. The absorbance of the ABTS+ solution was adjusted to 0.7 at 734 nm by diluting it with distilled water. Subsequently, 150 µL of the prepared sample solution (intact cells/cell-free extract) was added to 1.35 mL of ABTS+ solution and incubated at 37 °C for 10 min. The reaction mixtures were centrifuged at 5000× g for 10 min to remove the cells and the absorbance was measured at 734 nm. PBS with ABTS and without the sample was used as the control. The following formula was used to determine the ABTS radical scavenging activity:
2.13.4. Reducing Power Activity
The reducing power activity of the intact cells and their cell-free extracts were measured based on a previously reported method [28]. Briefly, 500 µL of 1% potassium ferricyanide and an equal volume of samples were mixed and incubated for 20 min at 50 °C. Then, 500 µL of 10% trichloroacetic acid solution was added, and the mixture was centrifuged at 3000× g for 5 min. Finally, after mixing 200 µL of 0.1% FeCl3 (Sigma-Aldrich, St. Louis, MO, USA) with 500 µL of the upper liquid layer from the centrifuged mixture, the absorbance was measured at 700 nm.
2.14. Determination of Antibacterial Activities
2.14.1. Antibacterial Activity of the L. reuteri PSC102 Culture Supernatant
We cultured 1% (v/v) L. reuteri PSC102 in MRS media for 24 h at 37 °C. The supernatant was collected by centrifugation (6000 rpm, 10 min, 4 °C) and filtered using a 0.45-µm-pore-size filter. The filtered supernatant was concentrated using a vacuum evaporator to reduce the volume by 10 times. The antibacterial activities were tested at different concentrations (×10, ×5, and ×1) against three E. coli strains (KVCC0306, KVCC0543, and KVCC1423) using the disk diffusion method. Briefly, 100 µL of overnight cultured E. coli (108 CFU/mL) were moistened on Mueller–Hinton agar (Becton, Dickinson and Company, Sparks, MD, USA) plates. Subsequently, 6-mm paper disks were soaked with 60 μL of the prepared supernatant sample, dried, and placed on the surface of the bacteria-swabbed plate. A standard ampicillin (10 µg) disk was used as the positive control, and a Mueller–Hinton broth (Becton, Dickinson and Company, Sparks, MD, USA)-treated paper disk was used as the negative control. After overnight incubation at 37 °C, the zone of inhibition was measured using slide calipers and expressed in millimeter (mm).
2.14.2. Time-Kill Assay in Cocultures
The enterotoxigenic E. coli strain KVCC0306 was cultured in LB media at 37 °C for 24 h and then adjusted to 103 or 105 CFU/mL. The L. reuteri PSC102 culture was adjusted to 103, 105, 107, or 109 CFU/mL and cocultured in tubes containing 10 mL of Iso-sentitest–MRS broth (9:1) at 37 °C for 24 h. The sampling was performed at different time points (0, 1, 6, 12, and 24 h) to determine the viable cell count. Sample aliquots (100 µL) were used to prepare 10-fold serial dilutions and poured onto LB agar plates. The bacterial colonies were enumerated and expressed as log CFU/mL after incubating the plate for 24 h at 37 °C. E. coli KVCC0306 inoculated in Iso-sentitest–MRS broth without any treatment was used as the normal control, while colistin (0.1 mg/mL) was used as the positive control.
2.15. Statistical Analysis
Statistical significance was determined by one-way analysis of variance using the GraphPad Prism software version 8 (GraphPad Software Inc., San Diego, CA, USA). A p value of <0.05 was considered statistically significant.
3. Results
3.1. Screening and Isolation of L.reuteri PSC102
A total of 154 (L0001–L0154) candidate strains were initially isolated from pig feces (100 samples). Then, eight Lactobacilli strains (L002, L0006, L0010, L0013, L0014, L0017, L0018, and L0102) were selected and phenotypically characterized (Table 1). The strains were identified as gram-positive, rod-shaped, noncatalase forming, and D- and L-lactic acid producers. To identify the potential probiotic LAB candidates, these strains were tested for their ability to produce protease, lipase, amylase, and phytase (Table 2). The strain L0102, i.e., Limosilactobacillus (formerly Lactobacillus) reuteri PSC102 (L. reuteri PSC102), was selected as the final probiotic LAB candidate as it produced the maximum amount of protease, lipase, amylase, and phytase. SEM revealed that L. reuteri PSC102 had a rod-shaped morphology (Figure 1).

Table 1.
Characterization of Lactobacilli strains isolated from pig fecal samples based on Gram staining, cell morphology, and acid production.

Table 2.
Enzymatic activities of the screened Lactobacilli strains.

Figure 1.
Scanning electron microscope (SEM) image showing the rod-shaped L. reuteri PSC102.
3.2. Identification of L. reuteri PSC102
The final selected strain was L. reuteri PSC102 (GenBank accession number: MZ127631.1). Figure 2 shows the base sequence analyzed via 16S rRNA gene sequencing (https://www.ncbi.nlm.nih.gov/nuccore/2032707025 (accessed on 12 May 2021). Comparing the GenBank data homology with sequences from the National Center for Biotechnology Information demonstrated that this strain belongs to L. reuteri with >99% sequence similarity [22].

Figure 2.
The base sequence of L. reuteri PSC102 analyzed using 16S rRNA gene sequencing.
3.3. Biochemical Characteristics of L. reuteri PSC102
The carbohydrate fermentation profile of L. reuteri PSC102 was determined using API 50 CHL medium with API 50 CH strips (Table 3). L. reuteri PSC102 exhibited a positive reaction for most carbohydrates, indicating that it could be used as a fermentation starter to produce active metabolites. Therefore, this strain could be efficiently used in industrial media for fermentation based on its glycolytic properties.

Table 3.
Carbohydrate fermentation profile of L. reuteri PSC102 using API 50 CHL.
3.4. Extracellular Enzyme Activities
The extracellular enzymatic profile of L. reuteri PSC102 was evaluated using the API-ZYM kit. As shown in Table 4, L. reuteri PSC102 showed the best extracellular enzymatic efficacy. The results demonstrated that among the 19 tested enzymes, leucine arylamidase and α-glucosidase were highly produced by the strain, followed by acid phosphatase, naphthol-AS-BI-phosphohydrolase, and α-galactosidase (moderately produced). The production of beneficial enzymes by L. reuteri PSC102 was higher than the production of those by the quality control strains L. reuteri KCTC 3594 and L. acidophilus KCTC 3146.

Table 4.
Enzymatic activities of L. reuteri PSC102 as determined using the API-ZYM kit.
3.5. Acid Resistance of L. reuteri PSC102
To function as a probiotic, the bacterial strain should survive low pH conditions (<pH 3) in the stomach. Therefore, we determined the survivability of L. reuteri PSC102 at low pH. As shown in Table 5, L. reuteri PSC102 strain survived for >6 h at strongly acidic pH (pH 2 and 3), indicating significantly higher acid resistance compared with that of the standard strain L. reuteri KCCM 40,717 (p < 0.05).

Table 5.
Tolerance of L. reuteri PSC102 to low pH.
3.6. Bile Salt Tolerance of L. reuteri PSC102
As resistance to bile salts is another important criterion for bacteria to be considered a potential probiotic, we determined the bile salt tolerance of L. reuteri PSC102 at different concentrations and time intervals. As shown in Table 6, L. reuteri PSC102 could survive even in 1% of bile salt, indicating that this strain possesses excellent bile tolerance.

Table 6.
Bile salt tolerance of L. reuteri PSC102.
3.7. Autoaggregation Ability
Autoaggregation was measured over a period of 24 h. The ability of L. reuteri PSC102 to autoaggregate increased with increased incubation time (Figure 3 and Figure 4). The strongest autoaggregation ability (84.93%) was observed at 24 h, indicating that L. reuteri PSC102 might efficiently adhere to mucosal surfaces and epithelial cells.

Figure 3.
Autoaggregation percentage of L. reuteri PSC102 measured at 2, 4, 6, 12, and 24 h of incubation at 37 °C. Data are expressed as mean ± standard deviation (n = 3).

Figure 4.
SEM image of autoaggregated L. reuteri PSC102.
3.8. Coaggregation Ability
L. reuteri PSC102 was able to coaggregate with pathogens, including enterotoxigenic E. coli. After 2 h of incubation, L. reuteri PSC102 coaggregated the most with E. coli KVCC0306 (9.02%), followed by S. aureus ATCC 35,218 (3.35%). After 24 h of incubation, L. reuteri PSC102 still coaggregated the most with the same two strains (E. coli KVCC0306 [81.13%] and S. aureus ATCC 35,218 [72.41%]; Table 7 and Figure 5).

Table 7.
Coaggregation percentage of L. reuteri PSC102 with different pathogenic bacteria as measured after 2 and 24 h of incubation at 37 °C.

Figure 5.
SEM image of L. reuteri PSC102 coaggregating with E. coli ATCC 35,218 (A), E. coli KVCC0306 (B), and S. aureus ATCC 29,213 (C).
3.9. Adhesion to Caco-2 Cells
The initial number of L. reuteri PSC102 was 1.14 ± 0.08 (×108) CFU/mL. After 3 h, the number of L. reuteri PSC102 adhering to Caco-2 cells was 4.6 ± 0.94 (×106) CFU/mL, with a 4.03% (±0.15) adhesion rate (Table 8). These results are consistent with those of previous studies, which showed that LAB could adhere to Caco-2 cells in the range of 2%–6% [28,29].

Table 8.
Adhesion of L. reuteri PSC102 to Caco-2 cells.
3.10. Antibiotic Sensitivity Test
Table 9 shows the sensitivity of L. reuteri PSC102 to various antibiotics. L. reuteri PSC102 strain was found to be resistant to cephalexin, colistin sulfate, norfloxacin, spectinomycin, gentamicin sulfate, and streptomycin sulfate. Moreover, L. reuteri PSC102 exhibited higher MIC and MBC values for most of the tested antibiotics than the control strains (L. reuteri KCCM 40,717, S. aureus ATCC 25,922, and enterotoxigenic E. coli KVCC0306) [30,31].

Table 9.
Minimal inhibitory concentration (MIC) and minimum bactericidal concentration (MBC) of L. reuteri PSC102 against various antibiotics.
3.11. Hemolytic and Gelatinase Activities
For the hemolytic activity assay, L. reuteri PSC102 was streaked on blood agar plates and incubated at 37 °C for 24 h. We did not observe clear zones (β-hemolysis) or green-hued zones (α-hemolysis) around the colonies (Figure 6A), indicating that L. reuteri PSC102 is not a hemolytic strain. Regarding the gelatinase activity, upon checking the plates after incubation, no opaque halos were observed around the colonies (Figure 6B).
Figure 6.
Hemolytic and gelatinase activity test. (A) Hemolytic activity: L. reuteri PSC102 (LR), positive control; Staphylococcus aureus (SA). (B) Gelatinase activity: L. reuteri PSC102 (LR), positive control; Bacillus subtilis (BS).
3.12. Antioxidant Activity
Figure 7 shows the DPPH and ABTS free radical scavenging activities of L. reuteri PSC102 intact cells and cell-free extracts. Intact L. reuteri PSC102 cells had higher DPPH radical-scavenging ability (34.31%) than the intracellular cell-free extracts (24.04%; Figure 7A). The ABTS radical scavenging effect of intact cells was 17.84%, which was more than double that of the intracellular cell-free extracts (6.86%; Figure 7B). The reducing power of the intact cells was 0.096, whereas that of the cell-free extracts was 0.076 (Figure 7C). The DPPH and ABTS free radical scavenging activities and reducing power of intact cells were higher than those of the cell-free extracts, indicating that more active components were present in the intact cells.

Figure 7.
Antioxidant activity of intact cells and cell-free extracts of L. reuteri PSC102 measured by (A) DPPH radical scavenging, (B) ABTS radical scavenging, and (C) reducing power assays. Different symbols (*, #) on the bars denote significant differences between groups (p < 0.05). Data are expressed as mean ± standard deviation (n = 3).
3.13. Antibacterial Activities of L. reuteri PSC102 Culture Supernatant
Evaluation of the potential antibacterial activities of the supernatants of L. reuteri PSC102 against three enterotoxigenic E. coli strains revealed that the supernatant possessed antibacterial activities against all three E. coli strains (Table 10). Among them, E. coli KVCC1423 was the most sensitive to ×10 concentrated supernatant (14.72-mm inhibition zone). Interestingly, E. coli KVCC0306 was resistant to standard ampicillin but was sensitive to the supernatant.

Table 10.
Antibacterial activities of L. reuteri PSC102 supernatant against enterotoxigenic pathogens evaluated using the disk diffusion method.
3.14. Time-Kill Assay
Figure 8 shows the results of the time-kill assay. After 24 h incubation, the growth of E. coli KVCC0306 did not change significantly. However, at 6 and 12 h, the growth of E. coli KVCC0306 (103 CFU/mL) was significantly inhibited by L. reuteri PSC102 (103, 105, 107, or 109 CFU/mL) compared with the normal control (p < 0.05; Figure 8A). With coculture of 105 CFU/mL E. coli KVCC0306 and different concentrations of L. reuteri PSC102, E. coli KVCC0306 was significantly inhibited by L. reuteri PSC102 at 6 h (p < 0.05; Figure 8B). The CFU/mL of E. coli KVCC0306 in the presence or absence of different concentrations of L. reuteri PSC102 was adjusted with the inhibitor vs. response model generated using the GraphPad Prism 8 software with the following equation:
where Top and Bottom are E. coli KVCC0306 CFU/mL in the absence of L. reuteri PSC102 and at maximum growth inhibition in the presence of L. reuteri PSC102, and IC50 is the minimum concentration of L. reuteri PSC102 needed to inhibit the growth of E. coli KVCC0306 by 50% in their coculture. For E. coli KVCC0306 (103 and 105 CFU/mL), the IC50 values of L. reuteri PSC102 were found to be 3.96 × 107 and 1.44 × 105 CFU/mL, respectively (Figure 8C,D).
Y = Bottom + ((Top − Bottom)/(1 + 10^(X − LogIC50)))

Figure 8.
Time-kill assay curves of coculture of L. reuteri PSC102 (LR) and enterotoxigenic pathogen E. coli KVCC0306. CFU changes of 103 CFU/mL (A) and 105 CFU/mL E. coli KVCC0306 (B) observed after coculture with four different concentrations of L. reuteri PSC102 (103, 105, 107, and 109 CFU/mL) for 24 h. The minimum concentration of L. reuteri PSC102 needed to inhibit the growth of E. coli KVCC0306 by 50% (IC50) when E. coli KVCC0306 cocultured at 103 CFU/mL (C) and 105 CFU/mL (D). Data are expressed as means ± standard deviation (n = 3). ** p < 0.01, and *** p < 0.001 vs. normal control (E. coli KVCC0306 103 CFU/mL or 105 CFU/mL culture alone).
4. Discussion
Probiotics are obtained after in vitro screening for evaluating several characteristics, such as the ability to produce digestive enzymes, inhibit various pathogens, tolerate bile salts and gastric acids, exhibit antimicrobial sensitivity, and provide safe and beneficial properties for the host [21,32]. In this study, Lactobacillus strains were initially isolated, and their phenotypic characteristics were evaluated. Thereafter, their ability to produce digestive enzymes, including lipase, phytase, amylase, and protease, was examined. We isolated 154 potential Lactobacillus probiotics from pig fecal samples and cultured them on MRS media. Further, we identified eight candidates based on their phenotypic characteristics and capacity to produce digestive enzymes. Finally, we identified L. reuteri PSC102 based on its ability to produce digestive enzymes. Biochemical evaluation of L. reuteri PSC102 using API 50 CHL showed that L. reuteri PSC102 possesses glycolytic capacity, suggesting that this strain can be successfully used for fermentation.
Probiotic bacteria have several health benefits for humans and other animals [33,34,35,36,37]. These bacteria should not produce enzymes such as β-glucuronidase, α-chymotrypsin, and N-acetyl-glucosaminidase, as these enzymes are potentially harmful [38]. As expected, L. reuteri PSC102 did not produce any harmful enzymes. Conversely, acid phosphatase, α-glucosidase, and β-galactosidase released by probiotics have been shown to be beneficial [39]. In particular, acid phosphatase, when used as a supplementary feed additive, increases the absorption of phosphorus in the feed, thereby reducing the use of inorganic phosphorus.
Probiotic strains must be able to survive in conditions similar to those found in the GI tract, by exhibiting tolerance to bile salts and low pH [40]. In addition to resisting low pH and changes in glycolytic flux, probiotic bacteria should maintain intracellular pH [41]. Low pH can increase the ammonium output in the cytoplasm, which is likely liberated during the deamination of amino acid. This reduces the activity of bile salt hydrolase [41]. H+-ATPase activity is also necessary for survival in an acidic environment [8]. Under acidic conditions, the H+-ATPase activity of acid-tolerant bacterial strains increases, whereas that of non-acid-tolerant strains decreases [42]. The H+-ATPase activity in the cells increases rapidly to sustain a stable intracellular pH by releasing H+ for acid-tolerant bacteria [42]. Tolerance to bile salts is important for Lactobacillus to grow, survive, and function during GI tract transit [43]. The most common mechanisms of bile salt tolerance in LAB are active efflux and hydrolysis of bile salts and alterations of the cell membrane and cell wall composition [44]. A previous study showed that different Lactobacillus species isolated from goat’s milk cheese can hydrolyze bile salts [7]. Interestingly, our tested L. reuteri PSC102 strain was resistant to low pH and high bile salt concentration, suggesting that this strain would likely survive the stomach passage and in the small intestine.
Autoaggregation and coaggregation abilities of bacteria are essential for several biological activities [45]. Via aggregation, bacteria may gain sufficient mass to form biofilms or adhere to the host’s intestinal mucosal surfaces, allowing them to perform their functions [46]. In our study, the autoaggregation of L. reuteri PSC102 increased with an increase in the incubation period. In a previous study, Lactobacilli autoaggregation was facilitated by proteins found in the culture supernatant and lipoproteins or proteins on the surface of the cells that were not washed off and resuspended in PBS [47]. Coaggregation enables bacteria to interact intimately with other bacteria [48]. In this study, the percentage of coaggregation of L. reuteri PSC102 with E. coli KVCC0306 was the highest after 2 and 24 h of incubation. This ability to coaggregate with pathogens might contribute to the probiotic potential of L. reuteri PSC102 by allowing it to establish a barrier and prevent the colonization of harmful bacteria [49,50].
The ability of probiotic bacteria to adhere to the intestinal epithelium mucosa and colonize is a significant characteristic as it prevents removal from the intestine by peristalsis [25,51]. In this study, the ability of L. reuteri PSC102 to adhere to intestinal mucosa was evaluated using Caco-2 cells, which proved that it could colonize in the intestine and maintain the intestinal microflora homeostasis of the host.
The functional qualities of probiotic strains should be assessed before in vivo administration. Antibiotic resistance is considered detrimental to human and animal health and food safety [28]. However, the antibiotic susceptibility of a probiotic is a critical factor in determining whether it can be coadministered with antibiotics [52]. In this study, LAB strains exhibited antibiotic reactivity, which is consistent with that reported by a previous study [53]. As L. reuteri PSC102 was resistant to the tested antibiotics, it can be used in combination with antibiotic-containing feed or feed additives and exert its probiotic effect. Moreover, in the presence of these antibiotics, L. reuteri PSC102 might survive and exert useful effects in the host [54].
As most probiotic bacteria are safe for consumption, the chances of infections are rare. However, hemolysis might occur if the ingested bacteria gains access to the blood, resulting in hemolytic symptoms, including fever, anemia, and skin rash [55]. Therefore, the hemolytic activity of probiotics must be assessed to guarantee their safety. Gelatinase activity is considered a risk factor as it indicates the potential to hydrolyze collagen, which may trigger an inflammatory reaction [56]. In this study, L. reuteri PSC102 did not show hemolytic and gelatinase activities, thus eliminating the safety issues regarding this strain.
Oxidative stress can harm cells by initiating DNA hydroxylation, lipid peroxidation, and protein denaturation. However, antioxidants can prevent or reduce oxidative damage [57]. LAB exert antioxidant effects by producing various active cell surface components, proteins, and antioxidant enzymes. This prevents or hinders the progress of different oxidative stress-related disorders [58]. LAB have been shown to possess strong DPPH and ABTS free radical scavenging activity, which might enhance the oxidative status of weaned piglets and improve their growth [59]. In our study, L. reuteri PSC102 demonstrated a strong free radical scavenging effect and reducing power. Hence, it might be potentially used to alleviate oxidative stress-induced disorders.
The growth-inhibitory activity of probiotics against target pathogens is a desirable property [60]. Our findings demonstrated that L. reuteri PSC102 could inhibit all the tested enterotoxigenic E. coli pathogenic strains. L. reuteri PSC102 cells and culture supernatant exhibited strong antibacterial activity against all three E. coli strains in a concentration-dependent manner. Despite E. coli KVCC0306 being resistant to standard ampicillin, the supernatant exhibited inhibitory activity against it. Therefore, we selected E. coli KVCC0306 for the time-kill assay by coculturing with live L. reuteri PSC102. The supernatant might contain different active metabolites with antimicrobial properties, such as organic acids (mainly lactic and acetic acids) and other metabolites, including p-coumaric, 3-phenylpropanoic, 3-phenyl lactic, D-glucuronic, and benzoic acids; cyclic dipeptides; and bacteriocins, all of which are potent antibacterial compounds [8,61]. The antibacterial activity of the supernatant is mediated by the rapid diffusion of the antimicrobial components across the microbial cell membrane. This activity significantly depends on the concentration of antimicrobial components and the number of pathogenic bacteria used for the assay [8]. The most notable metabolite produced by L. reuteri is reuterin, a broad-spectrum antimicrobial component that can kill many food-borne pathogens, including E. coli and S. aureus [62,63]. Rueterin exerts its activity by getting adsorbed by sensitive bacterial cells and disturbing their metabolism by depleting free sulfhydryl groups in bacterial proteins, thereby inducing oxidative stress and ultimately resulting in cell death [64]. Moreover, lactic and acetic acid production can lower the pH inside the cells, which can dissipate membrane function. The acidification of the cytoplasm might restrict bacterial growth by limiting glycolysis [65]. In the time-kill assay, cocultures of L. reuteri PSC102 with the enterotoxigenic pathogen E. coli inhibited the growth of E. coli KVCC0306 for up to 12 h. During coculture, different organic compounds were produced, which might permeabilize the outer membrane of gram-negative bacteria, such as E. coli, and enhance the activities of other antibacterial metabolites [66]. Therefore, this L. reuteri strain might effectively treat enterotoxigenic E. coli-induced diarrhea in pigs.
5. Conclusions
In this study, we isolated and identified L. reuteri PSC102, which showed excellent characteristics, including autoaggregation and coaggregation, adhesion to Caco-2 cells, and resistance to in vitro GI tract conditions. The strain did not exhibit any hemolytic and gelatinase activity or produce any undesirable extracellular enzymes. The intact L. reuteri PSC102 cells and their cell-free extracts showed promising antioxidant activities. Moreover, both the strain and its supernatant exhibited antibacterial activities against enterotoxigenic E. coli. These results suggest that L. reuteri PSC102 is an efficient probiotic candidate that can aid in the development of functional feeds. As this strain has been isolated from swine, it could be preferentially used in swine as a growth promoter and an antibiotic alternative.
Author Contributions
Conceptualization, S.-C.P., M.S.A. and E.-B.L.; methodology, M.S.A. and E.-B.L.; software, M.S.A. and S.-K.L.; validation, K.S. and S.-K.L.; investigation, S.-C.P., M.S.A. and E.-B.L.; resources, S.-C.P.; data curation, M.S.A. and E.-B.L.; writing—original draft preparation, M.S.A. and E.-B.L.; writing—review and editing, S.-C.P., K.S. and S.-K.L.; supervision, S.-C.P. and K.S.; and funding acquisition, S.-C.P. All authors have read and agreed to the published version of the manuscript.
Funding
This work was supported by the Korean Institute of Planning and Evaluation for Technology in Food, Agriculture and Forestry (IPET) through Companion Animal Life Cycle Industry Technology Development Program (322098-03) and by a grant (Z-1543081-2020-22-02) from the Animal and Plant Quarantine Agency, Ministry of Agriculture, Food and Rural Affairs, Republic of Korea.
Institutional Review Board Statement
Not applicable.
Informed Consent Statement
Not applicable.
Data Availability Statement
All data generated for this study are contained within the article.
Conflicts of Interest
The authors declare no conflict of interest.
References
- Mingmongkolchai, S.; Panbangred, W. Bacillus Probiotics: An Alternative to Antibiotics for Livestock Production. J. Appl. Microbiol. 2018, 124, 1334–1346. [Google Scholar] [CrossRef] [PubMed]
- Cho, J.H.; Zhao, P.Y.; Kim, I.H. Probiotics as a Dietary Additive for Pigs: A Review. J. Anim. Vet. Adv. 2011, 10, 2127–2134. [Google Scholar] [CrossRef]
- Guerra, N.P.; Bernárdez, P.F.; Méndez, J.; Cachaldora, P.; Castro, L.P. Production of Four Potentially Probiotic Lactic Acid Bacteria and Their Evaluation as Feed Additives for Weaned Piglets. Anim. Feed Sci. Technol. 2007, 134, 89–107. [Google Scholar] [CrossRef]
- Lim, Y.H.; Foo, H.L.; Loh, T.C.; Mohamad, R.; Abdullah, N. Comparative Studies of Versatile Extracellular Proteolytic Activities of Lactic Acid Bacteria and Their Potential for Extracellular Amino Acid Productions as Feed Supplements. J. Anim. Sci. Biotechnol. 2019, 10, 15. [Google Scholar] [CrossRef]
- Hou, C.; Zeng, X.; Yang, F.; Liu, H.; Qiao, S. Study and Use of the Probiotic Lactobacillus reuteri in Pigs: A Review. J. Anim. Sci. Biotechnol. 2015, 6, 14. [Google Scholar] [CrossRef] [PubMed]
- Markowiak, P.; Śliżewska, K. The Role of Probiotics, Prebiotics and Synbiotics in Animal Nutrition. Gut Pathog. 2018, 10, 21. [Google Scholar] [CrossRef] [PubMed]
- Lavilla-Lerma, L.; Pérez-Pulido, R.; Martínez-Bueno, M.; Maqueda, M.; Valdivia, E. Characterization of Functional, Safety, and Gut Survival Related Characteristics of Lactobacillus Strains Isolated from Farmhouse Goat’s Milk Cheeses. Int. J. Food Microbiol. 2013, 163, 136–145. [Google Scholar] [CrossRef]
- Cizeikiene, D.; Jagelaviciute, J. Investigation of Antibacterial Activity and Probiotic Properties of Strains Belonging to Lactobacillus and Bifidobacterium Genera for Their Potential Application in Functional Food and Feed Products. Probiotics Antimicrob. Proteins 2021, 13, 1387–1403. [Google Scholar] [CrossRef]
- Wang, J.; Ji, H.F.; Wang, S.X.; Zhang, D.Y.; Liu, H.; Shan, D.C.; Wang, Y.M. Lactobacillus plantarum ZLP001: In Vitro Assessment of Antioxidant Capacity and Effect on Growth Performance and Antioxidant Status in Weaning Piglets. Asian Australas. J. Anim. Sci. 2012, 25, 1153. [Google Scholar] [CrossRef]
- Firuzi, O.; Miri, R.; Tavakkoli, M.; Saso, L. Antioxidant Therapy: Current Status and Future Prospects. Curr. Med. Chem. 2011, 18, 3871–3888. [Google Scholar] [CrossRef]
- Pisoschi, A.M.; Pop, A. The Role of Antioxidants in the Chemistry of Oxidative Stress: A Review. Eur. J. Med. Chem. 2015, 97, 55–74. [Google Scholar] [CrossRef] [PubMed]
- Valeriano, V.D.V.; Balolong, M.P.; Kang, D. Probiotic Roles of Lactobacillus Sp. in Swine: Insights from Gut Microbiota. J. Appl. Microbiol. 2017, 122, 554–567. [Google Scholar] [CrossRef] [PubMed]
- Ohland, C.L.; MacNaughton, W.K. Probiotic Bacteria and Intestinal Epithelial Barrier Function. Am. J. Physiol. Liver Physiol. 2010, 298, G807–G819. [Google Scholar] [CrossRef] [PubMed]
- Pietrangelo, L.; Magnifico, I.; Petronio Petronio, G.; Cutuli, M.A.; Venditti, N.; Nicolosi, D.; Perna, A.; Guerra, G.; Di Marco, R. A Potential “Vitaminic Strategy” against Caries and Halitosis. Appl. Sci. 2022, 12, 2457. [Google Scholar] [CrossRef]
- Yong, C.-C.; Khoo, B.-Y.; Sasidharan, S.; Piyawattanametha, W.; Kim, S.-H.; Khemthongcharoen, N.; Chuah, L.-O.; Ang, M.-Y.; Liong, M.-T. Activity of Crude and Fractionated Extracts by Lactic Acid Bacteria (LAB) Isolated from Local Dairy, Meat, and Fermented Products against Staphylococcus aureus. Ann. Microbiol. 2015, 65, 1037–1047. [Google Scholar] [CrossRef]
- Marianelli, C.; Cifani, N.; Pasquali, P. Evaluation of Antimicrobial Activity of Probiotic Bacteria against Salmonella enterica subsp. enterica Serovar Typhimurium 1344 in a Common Medium under Different Environmental Conditions. Res. Microbiol. 2010, 161, 673–680. [Google Scholar] [CrossRef]
- Servin, A.L. Antagonistic Activities of Lactobacilli and Bifidobacteria against Microbial Pathogens. FEMS Microbiol. Rev. 2004, 28, 405–440. [Google Scholar] [CrossRef]
- Hyronimus, B.; Le Marrec, C.; Hadj Sassi, A.; Deschamps, A. Acid and Bile Tolerance of Spore-Forming Lactic Acid Bacteria. Int. J. Food Microbiol. 2000, 61, 193–197. [Google Scholar] [CrossRef]
- Abbas, M.A.; Lee, E.-B.; Boby, N.; Biruhanu, B.T.; Park, S.-C. A Pharmacodynamic Investigation to Assess the Synergism of Orbifloxacin and Propyl Gallate against Escherichia coli. Front. Pharmacol. 2022, 13, 989395. [Google Scholar] [CrossRef]
- Kim, E.-Y.; Kim, Y.-H.; Rhee, M.-H.; Song, J.-C.; Lee, K.-W.; Kim, K.-S.; Lee, S.-P.; Lee, I.-S.; Park, S.-C. Selection of Lactobacillus sp. PSC101 That Produces Active Dietary Enzymes Such as Amylase, Lipase, Phytase and Protease in Pigs. J. Gen. Appl. Microbiol. 2007, 53, 111–117. [Google Scholar] [CrossRef]
- Lee, J.-S.; Damte, D.; Lee, S.-J.; Hossain, M.-A.; Belew, S.; Kim, J.-Y.; Rhee, M.-H.; Kim, J.-C.; Park, S.-C. Evaluation and Characterization of a Novel Probiotic Lactobacillus pentosus PL11 Isolated from Japanese Eel (Anguilla japonica) for Its Use in Aquaculture. Aquac. Nutr. 2015, 21, 444–456. [Google Scholar] [CrossRef]
- Ali, M.S.; Lee, E.-B.; Quah, Y.; Birhanu, B.T.; Suk, K.; Lim, S.-K.; Park, S.-C. Heat-Killed Limosilactobacillus reuteri PSC102 Ameliorates Impaired Immunity in Cyclophosphamide-Induced Immunosuppressed Mice. Front. Microbiol. 2022, 13, 820838. [Google Scholar] [CrossRef] [PubMed]
- Kondrotiene, K.; Lauciene, L.; Andruleviciute, V.; Kasetiene, N.; Serniene, L.; Sekmokiene, D.; Malakauskas, M. Safety Assessment and Preliminary in Vitro Evaluation of Probiotic Potential of Lactococcus Lactis Strains Naturally Present in Raw and Fermented Milk. Curr. Microbiol. 2020, 77, 3013–3023. [Google Scholar] [CrossRef]
- Jena, P.K.; Trivedi, D.; Thakore, K.; Chaudhary, H.; Giri, S.S.; Seshadri, S. Isolation and Characterization of Probiotic Properties of Lactobacilli Isolated from Rat Fecal Microbiota. Microbiol. Immunol. 2013, 57, 407–416. [Google Scholar] [CrossRef] [PubMed]
- Barik, A.; Patel, G.D.; Sen, S.K.; Rajhans, G.; Nayak, C.; Raut, S. Probiotic Characterization of Indigenous Kocuria flava Y4 Strain Isolated from Dioscorea villosa Leaves. Probiotics Antimicrob. Proteins 2021, 1–16. [Google Scholar] [CrossRef]
- Hossain, M.A.; Park, H.-C.; Park, S.-W.; Park, S.-C.; Seo, M.-G.; Her, M.; Kang, J. Synergism of the Combination of Traditional Antibiotics and Novel Phenolic Compounds against Escherichia coli. Pathogens 2020, 9, 811. [Google Scholar] [CrossRef]
- Perin, L.M.; Miranda, R.O.; Todorov, S.D.; de Melo Franco, B.D.G.; Nero, L.A. Virulence, Antibiotic Resistance and Biogenic Amines of Bacteriocinogenic Lactococci and Enterococci Isolated from Goat Milk. Int. J. Food Microbiol. 2014, 185, 121–126. [Google Scholar] [CrossRef]
- Tian, L.; Liu, R.; Zhou, Z.; Xu, X.; Feng, S.; Kushmaro, A.; Marks, R.S.; Wang, D.; Sun, Q. Probiotic Characteristics of Lactiplantibacillus Plantarum N-1 and Its Cholesterol-Lowering Effect in Hypercholesterolemic Rats. Probiotics Antimicrob. Proteins 2022, 14, 337–348. [Google Scholar] [CrossRef]
- Son, S.-H.; Yang, S.-J.; Jeon, H.-L.; Yu, H.-S.; Lee, N.-K.; Park, Y.-S.; Paik, H.-D. Antioxidant and Immunostimulatory Effect of Potential Probiotic Lactobacillus paraplantarum SC61 Isolated from Korean Traditional Fermented Food, jangajji. Microb. Pathog. 2018, 125, 486–492. [Google Scholar] [CrossRef]
- Clinical and Laboratory Standards Institute. Performance Standards for Antimicrobial Susceptibility Testing. Clin. Lab Stand. Inst. 2016, 35, 16–38. [Google Scholar]
- European Committee on Antimicrobial Susceptibility Testing. Breakpoint Tables for Interpretation of MICs and Zone Diameters. 2019. Available online: https://www.eucast.org/clinical_breakpoints/ (accessed on 27 November 2022).
- Ghanbari, M.; Rezaei, M.; Jami, M.; Nazari, R.M. Isolation and Characterization of Lactobacillus Species from Intestinal Contents of Beluga (Huso huso) and Persian Sturgeon (Acipenser persicus). Iran. J. Vet. Res. 2009, 10, 152–157. [Google Scholar]
- Aragón, F.; Carino, S.; Perdigón, G.; de Moreno de LeBlanc, A. Inhibition of Growth and Metastasis of Breast Cancer in Mice by Milk Fermented with Lactobacillus casei CRL 431. J. Immunother. 2015, 38, 185–196. [Google Scholar] [CrossRef] [PubMed]
- Park, M.S.; Kwon, B.; Ku, S.; Ji, G.E. The Efficacy of Bifidobacterium longum BORI and Lactobacillus acidophilus AD031 Probiotic Treatment in Infants with Rotavirus Infection. Nutrients 2017, 9, 887. [Google Scholar] [CrossRef] [PubMed]
- So, S.S.Y.; Wan, M.L.Y.; El-Nezami, H. Probiotics-Mediated Suppression of Cancer. Curr. Opin. Oncol. 2017, 29, 62–72. [Google Scholar] [CrossRef]
- Galdeano, C.M.; Cazorla, S.I.; Dumit, J.M.L.; Vélez, E.; Perdigón, G. Beneficial Effects of Probiotic Consumption on the Immune System. Ann. Nutr. Metab. 2019, 74, 115–124. [Google Scholar]
- Venditti, N.; Vergalito, F.; Magnifico, I.; Cutuli, M.A.; Pietrangelo, L.; Cozzolino, A.; Angiolillo, A.; Succi, M.; Petronio, G.P.; Di Marco, R. The Lepidoptera Galleria Mellonella “In Vivo” Model: A Preliminary Pilot Study on Oral Administration of Lactobacillus plantarum (Now Lactiplantibacillus plantarum). New Microbiol. 2021, 44, 42–50. [Google Scholar]
- Lee, Y.; Choi, Y.; Yoon, Y. Lactic Acid Bacteria in Kimchi Might Be a Cause for Carcinogen Production in Intestine. Food Control 2021, 126, 108045. [Google Scholar] [CrossRef]
- Delgado, S.; O’sullivan, E.; Fitzgerald, G.; Mayo, B. In Vitro Evaluation of the Probiotic Properties of Human Intestinal Bifidobacterium Species and Selection of New Probiotic Candidates. J. Appl. Microbiol. 2008, 104, 1119–1127. [Google Scholar] [CrossRef]
- Argyri, A.A.; Zoumpopoulou, G.; Karatzas, K.-A.G.; Tsakalidou, E.; Nychas, G.-J.E.; Panagou, E.Z.; Tassou, C.C. Selection of Potential Probiotic Lactic Acid Bacteria from Fermented Olives by in Vitro Tests. Food Microbiol. 2013, 33, 282–291. [Google Scholar] [CrossRef]
- Sánchez, B.; Champomier-Vergès, M.-C.; Collado, M.D.C.; Anglade, P.; Baraige, F.; Sanz, Y.; de los Reyes-Gavilán, C.G.; Margolles, A.; Zagorec, M. Low-PH Adaptation and the Acid Tolerance Response of Bifidobacterium longum Biotype Longum. Appl. Environ. Microbiol. 2007, 73, 6450–6459. [Google Scholar] [CrossRef]
- Matsumoto, M.; Ohishi, H.; Benno, Y. H+-ATPase Activity in Bifidobacterium with Special Reference to Acid Tolerance. Int. J. Food Microbiol. 2004, 93, 109–113. [Google Scholar] [CrossRef] [PubMed]
- Bao, Y.; Zhang, Y.; Zhang, Y.; Liu, Y.; Wang, S.; Dong, X.; Wang, Y.; Zhang, H. Screening of Potential Probiotic Properties of Lactobacillus fermentum Isolated from Traditional Dairy Products. Food Control 2010, 21, 695–701. [Google Scholar] [CrossRef]
- Ruiz, L.; Margolles, A.; Sánchez, B. Bile Resistance Mechanisms in Lactobacillus and Bifidobacterium. Front. Microbiol. 2013, 4, 396. [Google Scholar] [CrossRef] [PubMed]
- Cozzolino, A.; Vergalito, F.; Tremonte, P.; Iorizzo, M.; Lombardi, S.J.; Sorrentino, E.; Luongo, D.; Coppola, R.; Di Marco, R.; Succi, M. Preliminary Evaluation of the Safety and Probiotic Potential of Akkermansia muciniphila DSM 22959 in Comparison with Lactobacillus rhamnosus GG. Microorganisms 2020, 8, 189. [Google Scholar] [CrossRef] [PubMed]
- Grześkowiak, Ł.; Collado, M.C.; Salminen, S. Evaluation of Aggregation Abilities between Commensal Fish Bacteria and Pathogens. Aquaculture 2012, 356, 412–414. [Google Scholar] [CrossRef]
- Kos, B.; Šušković, J.; Vuković, S.; Šimpraga, M.; Frece, J.; Matošić, S. Adhesion and Aggregation Ability of Probiotic Strain Lactobacillus acidophilus M92. J. Appl. Microbiol. 2003, 94, 981–987. [Google Scholar] [CrossRef]
- Reuben, R.C.; Roy, P.C.; Sarkar, S.L.; Rubayet Ul Alam, A.S.M.; Jahid, I.K. Characterization and Evaluation of Lactic Acid Bacteria from Indigenous Raw Milk for Potential Probiotic Properties. J. Dairy Sci. 2020, 103, 1223–1237. [Google Scholar] [CrossRef]
- Collado, M.C.; Meriluoto, J.; Salminen, S. Measurement of Aggregation Properties between Probiotics and Pathogens: In Vitro Evaluation of Different Methods. J. Microbiol. Methods 2007, 71, 71–74. [Google Scholar] [CrossRef]
- Schellenberg, J.; Smoragiewicz, W.; Karska-Wysocki, B. A Rapid Method Combining Immunofluorescence and Flow Cytometry for Improved Understanding of Competitive Interactions between Lactic Acid Bacteria (LAB) and Methicillin-Resistant S. aureus (MRSA) in Mixed Culture. J. Microbiol. Methods 2006, 65, 1–9. [Google Scholar] [CrossRef]
- Han, S.; Lu, Y.; Xie, J.; Fei, Y.; Zheng, G.; Wang, Z.; Liu, J.; Lv, L.; Ling, Z.; Berglund, B. Probiotic Gastrointestinal Transit and Colonization after Oral Administration: A Long Journey. Front. Cell. Infect. Microbiol. 2021, 11, 609722. [Google Scholar] [CrossRef]
- Śliżewska, K.; Chlebicz-Wójcik, A.; Nowak, A. Probiotic Properties of New Lactobacillus Strains Intended to Be Used as Feed Additives for Monogastric Animals. Probiotics Antimicrob. Proteins 2021, 13, 146–162. [Google Scholar] [CrossRef] [PubMed]
- Klare, I.; Konstabel, C.; Werner, G.; Huys, G.; Vankerckhoven, V.; Kahlmeter, G.; Hildebrandt, B.; Müller-Bertling, S.; Witte, W.; Goossens, H. Antimicrobial Susceptibilities of Lactobacillus, Pediococcus and Lactococcus Human Isolates and Cultures Intended for Probiotic or Nutritional Use. J. Antimicrob. Chemother. 2007, 59, 900–912. [Google Scholar] [CrossRef] [PubMed]
- Kumherová, M.; Veselá, K.; Kosová, M.; Mašata, J.; Horáčková, Š.; Šmidrkal, J. Novel Potential Probiotic Lactobacilli for Prevention and Treatment of Vulvovaginal Infections. Probiotics Antimicrob. Proteins 2021, 13, 163–172. [Google Scholar] [CrossRef] [PubMed]
- Kodner, C.; Kudrimoti, A. Diagnosis and Management of Acute Interstitial Nephritis. Am. Fam. Physician 2003, 67, 2527–2534. [Google Scholar] [PubMed]
- Barbosa, J.; Gibbs, P.A.; Teixeira, P. Virulence Factors among Enterococci Isolated from Traditional Fermented Meat Products Produced in the North of Portugal. Food Control 2010, 21, 651–656. [Google Scholar] [CrossRef]
- Wang, Y.; Wu, Y.; Wang, Y.; Xu, H.; Mei, X.; Yu, D.; Wang, Y.; Li, W. Antioxidant Properties of Probiotic Bacteria. Nutrients 2017, 9, 521. [Google Scholar] [CrossRef]
- Nakagawa, H.; Miyazaki, T. Beneficial Effects of Antioxidative Lactic Acid Bacteria. AIMS Microbiol. 2017, 3, 1–7. [Google Scholar] [CrossRef]
- Wang, A.N.; Yi, X.W.; Yu, H.F.; Dong, B.; Qiao, S.Y. Free Radical Scavenging Activity of Lactobacillus fermentum in Vitro and Its Antioxidative Effect on Growing–Finishing Pigs. J. Appl. Microbiol. 2009, 107, 1140–1148. [Google Scholar] [CrossRef]
- Halder, D.; Mandal, M.; Chatterjee, S.S.; Pal, N.K.; Mandal, S. Indigenous Probiotic Lactobacillus Isolates Presenting Antibiotic like Activity against Human Pathogenic Bacteria. Biomedicines 2017, 5, 31. [Google Scholar] [CrossRef]
- Ma, T.; Suzuki, Y.; Guan, L.L. Dissect the Mode of Action of Probiotics in Affecting Host-Microbial Interactions and Immunity in Food Producing Animals. Vet. Immunol. Immunopathol. 2018, 205, 35–48. [Google Scholar] [CrossRef]
- Langa, S.; Martín-Cabrejas, I.; Montiel, R.; Peirotén, Á.; Arqués, J.L.; Medina, M. Protective Effect of Reuterin-Producing Lactobacillus Reuteri against Listeria Monocytogenes and Escherichia coli O157:H7 in Semi-Hard Cheese. Food Control 2018, 84, 284–289. [Google Scholar] [CrossRef]
- Bennett, S.; Ben Said, L.; Lacasse, P.; Malouin, F.; Fliss, I. Susceptibility to Nisin, Bactofencin, Pediocin and Reuterin of Multidrug Resistant Staphylococcus aureus, Streptococcus dysgalactiae and Streptococcus uberis Causing Bovine Mastitis. Antibiotics 2021, 10, 1418. [Google Scholar] [CrossRef] [PubMed]
- Schaefer, L.; Auchtung, T.A.; Hermans, K.E.; Whitehead, D.; Borhan, B.; Britton, R.A. The Antimicrobial Compound Reuterin (3-Hydroxypropionaldehyde) Induces Oxidative Stress via Interaction with Thiol Groups. Microbiology 2010, 156, 1589. [Google Scholar] [CrossRef] [PubMed]
- Šušković, J.; Kos, B.; Beganović, J.; Leboš Pavunc, A.; Habjanič, K.; Matošić, S. Antimicrobial Activity–the Most Important Property of Probiotic and Starter Lactic Acid Bacteria. Food Technol. Biotechnol. 2010, 48, 296–307. [Google Scholar]
- Alakomi, H.-L.; Skytta, E.; Saarela, M.; Mattila-Sandholm, T.; Latva-Kala, K.; Helander, I.M. Lactic Acid Permeabilizes Gram-Negative Bacteria by Disrupting the Outer Membrane. Appl. Environ. Microbiol. 2000, 66, 2001–2005. [Google Scholar] [CrossRef]
Disclaimer/Publisher’s Note: The statements, opinions and data contained in all publications are solely those of the individual author(s) and contributor(s) and not of MDPI and/or the editor(s). MDPI and/or the editor(s) disclaim responsibility for any injury to people or property resulting from any ideas, methods, instructions or products referred to in the content. |
© 2023 by the authors. Licensee MDPI, Basel, Switzerland. This article is an open access article distributed under the terms and conditions of the Creative Commons Attribution (CC BY) license (https://creativecommons.org/licenses/by/4.0/).








